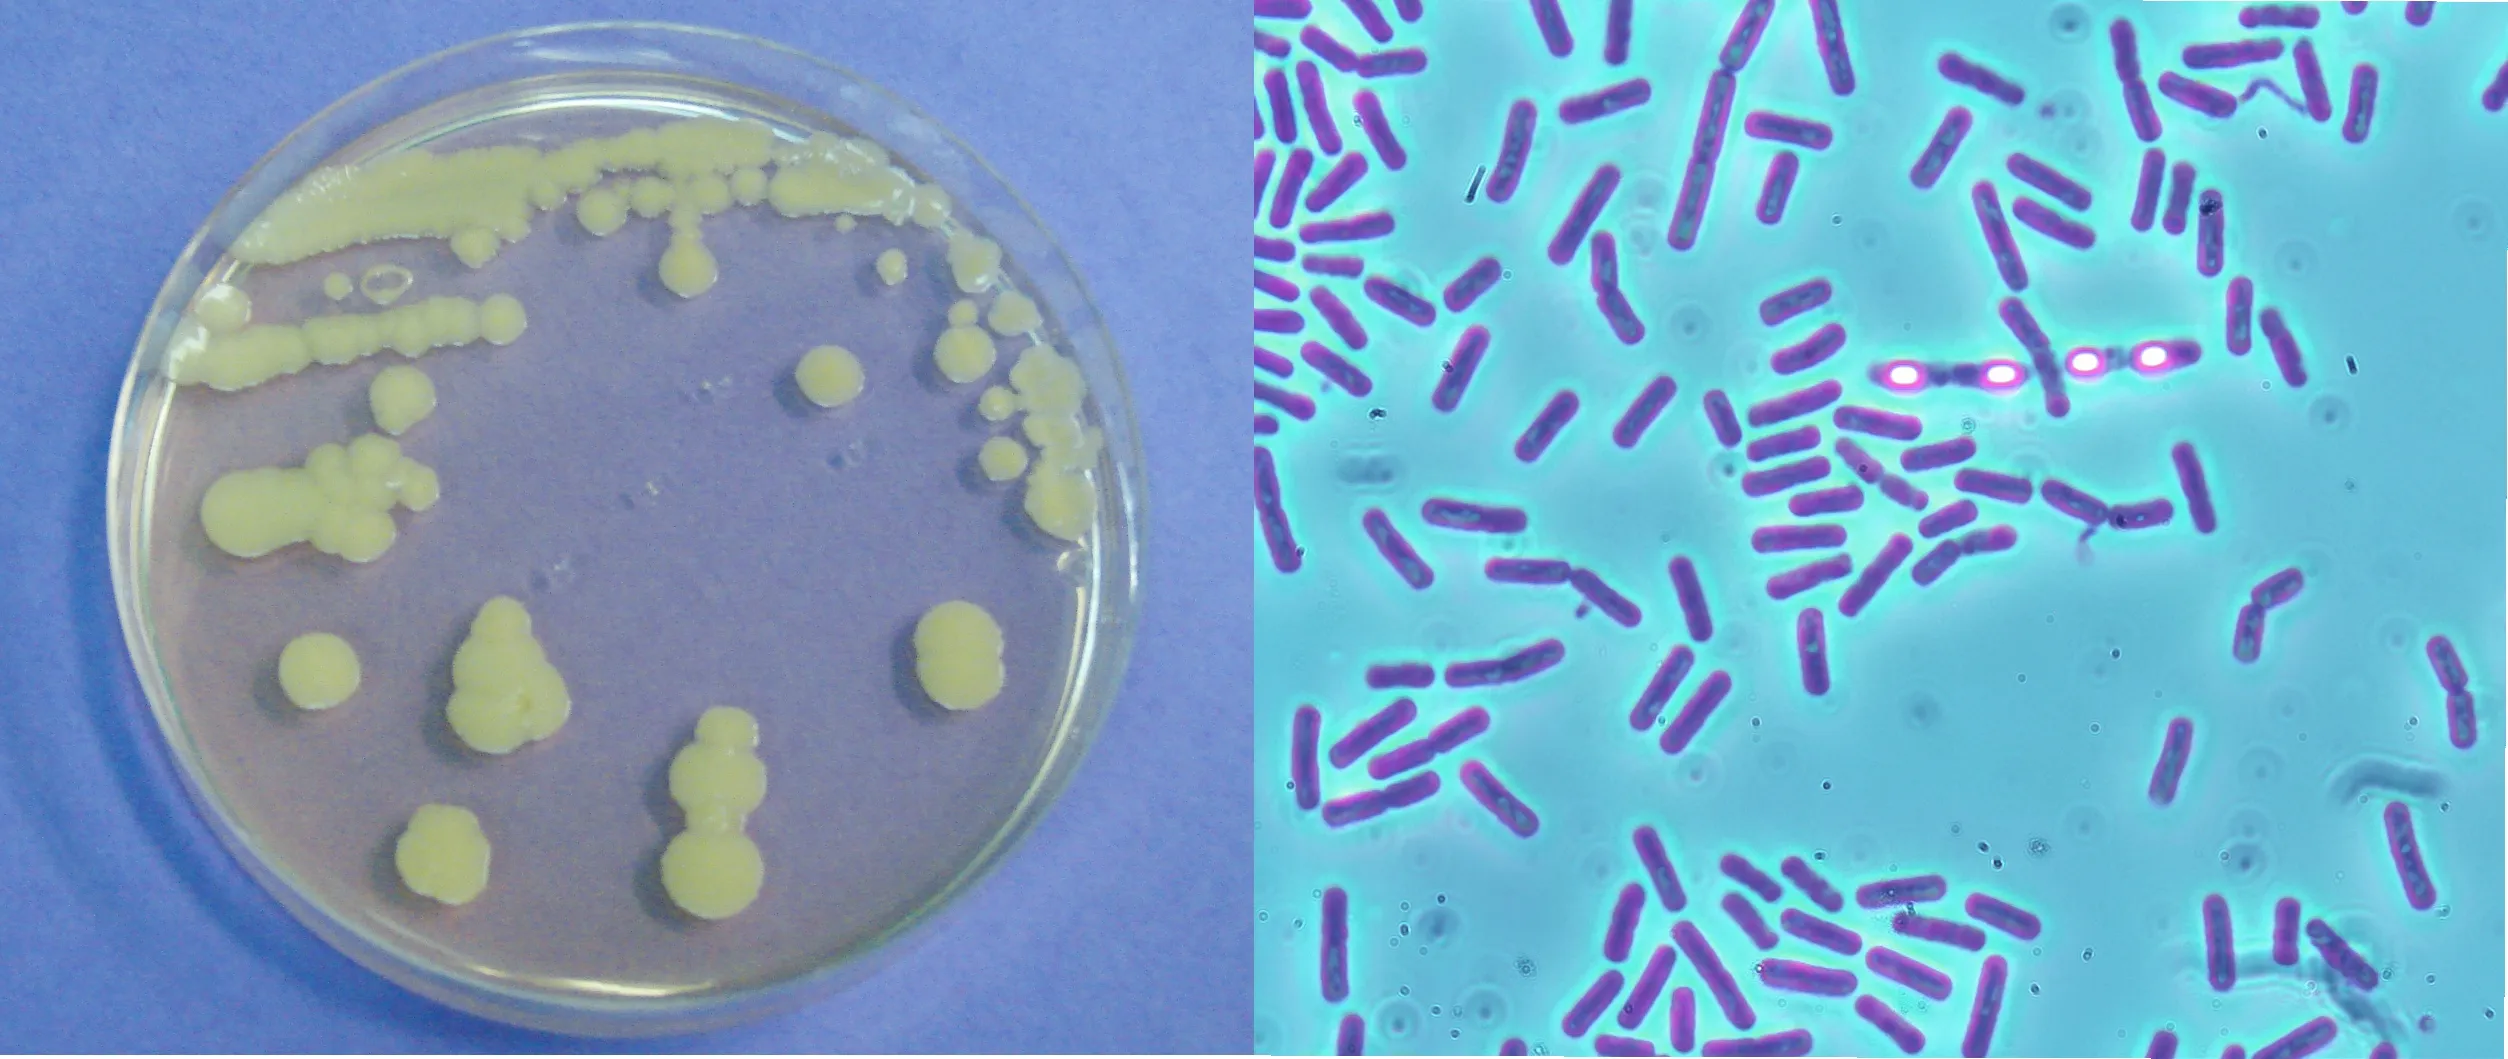
fig_5

Fermentación en la colmena: los microbios que nutren a las abejas
César Canché-Collí, Jorge Ramírez-Pech y Alejandro Pereira-Santana
Las abejas productoras de miel recolectan de las flores el polen y el néctar necesarios para satisfacer sus requerimientos alimenticios (Figura 1). Es común ver a las abejas buscando alimento en las áreas con vegetación natural, áreas de cultivo, parques, jardines, etc. Te has preguntado alguna vez ¿Qué hacen las abejas con el polen que recolectan? ¿Cómo lo consumen? ¿Existen microbios en ese polen? ¿Y cómo la biotecnología se relaciona con este tema?

Figura 1. Recolección de polen y néctar de la abeja sin aguijón Melipona beecheii. Fotografía: J. Ramírez-Pech.
Para empezar, debemos mencionar que el polen recolectado por las abejas no es consumido directamente como alimento. ¿Entonces qué es lo que ocurre? Cuando las abejas recogen el polen de las flores, lo humedecen con saliva y néctar, y lo adhieren a sus patas traseras para transportarlo hasta su colonia (Figura 2).

Figura 2. Abeja sin aguijón Melipona yucatanica transportando el polen recolectado en las patas traseras. Fotografía: J. Ramírez-Pech.
En la colonia, la carga de polen es almacenada en estructuras especiales; las abejas Apis lo hacen en celdas hexagonales, las abejas sin aguijón (como Frieseomelitta nigra) lo hacen en estructuras esféricas llamadas “potes” y las abejas solitarias en celdas (Figura 3). Cuando las celdas y los potes están llenos de polen son recubiertos con cera o cerumen (el cual es cera más resina) hasta cerrarlos por completo.

Figura 3. Pan de abeja producido en una colonia de Melipona beecheii. Fotografía: J. Ramírez-Pech.
En estas estructuras las condiciones de oxígeno son escasas (anaerobias) y el polen experimenta un proceso de fermentación láctica (parecido al del yogurt) que cambia sus características físicas y químicas, como el pH, la concentración de azúcares, la humedad, la digestibilidad, etc. Después de dos semanas, el polen transformado recibe el nombre de “pan de abeja” y las abejas lo consumen como un alimento de reserva [1] (Figura 4). Este alimento es esencial en las colonias de abejas porque aporta proteínas, carbohidratos, lípidos, vitaminas, entre otros.

Figura 4. Estructuras de almacenamiento de polen (flecha verde) en diferentes grupos de abejas. Celdas hexagonales en Apis mellifera (izquierda), potes esféricos en Frieseomelitta nigra (centro) y celdas (derecha) de abejas solitarias como Euglossa. Fotografías: C. Canché-Collí, M. Vázquez-Cetina y J. Ramírez-Pech.
La transformación del polen se atribuye, en parte, a la presencia de enzimas producidas por las abejas (p. ej. amilasas); no obstante, el proceso completo aún se desconoce. Un fenómeno interesante es que en el pan de abeja hay muchos microorganismos, y algunos pudieran influir en procesos claves de esta transformación, como la fermentación acido-láctica (que es la transformación de azúcares en ácido láctico). Al respecto, los científicos han hallado bacterias ácido-lácticas (BAL) como Lactobacillus sp. [4], y también levaduras como Candida sp., en las diferentes etapas de la transformación del pan de abeja.
Conocer la identidad de todos los microbios del pan de abeja no es una tarea fácil. Además, estos pueden ser diferentes entre las distintas especies de abejas que acumulan polen. En este punto entra en juego la biotecnología y sus diferentes herramientas que han permitido ganar conocimiento mediante investigaciones realizadas en abejas como Apis mellifera, y también en las abejas sin aguijón (llamadas meliponinos), que son polinizadoras nativas en las regiones mesoamericanas.
¿Cómo se estudian los microorganismos en el pan de abeja?
Para estudiar a estos microbios es posible emplear técnicas microbiológicas de aislamiento o tecnologías de secuenciación. La primera estrategia consiste en cultivar muestras de pan de abeja sobre medios de crecimiento formulados con nutrientes específicos, que se depositan en recipientes llamados cajas de Petri. Después de un período de incubación, el crecimiento de los microbios en las cajas confirmará su presencia [2] (Figura 5). El cultivo de los microbios permite realizar análisis complementarios para ganar más información; por ejemplo, pruebas de asimilación de azúcares. No obstante, muchos microbios no son cultivables, así que esta técnica tiene limitaciones.
Figura 5. Las técnicas microbiológicas nos permiten observar las colonias (izquierda) que forman los microbios aislados del pan de abeja, así como la morfología de sus células (derecha) con ayuda de un microscopio. Fotografías: C. Canché-Collí.
Descubrir la presencia de microorganismos en el pan de abeja a través de su ADN es la segunda y más moderna estrategia que se emplea, con ayuda de metodologías biotecnológicas. Los ácidos nucleicos, como el ADN y el ARN, contienen la información genética que define las características y funciones de los organismos. En ciertos contextos, el ADN puede usarse como un “código de barras molecular”, que permite identificar a las distintas especies [3]. Por ejemplo, para identificar a las bacterias, la secuenciación del ADN se enfoca en el gen ADNr 16S (ADN ribosomal), que, aunque está presente en todas ellas, tiene ligeras variaciones entra las especies, esto es, su secuencia (el código de barras) es diferente entre una bacteria y otra.
La información contenida en la secuencia del gen ADNr 16S puede obtenerse siguiendo diferentes procedimientos de biología molecular (Figura 6).

Figura 6. Procedimientos realizados (paso 1 al 4) durante la secuenciación del ADN. Crédito: C. Canché-Collí. Imagen creada en IA Gemini 2.5 Flash.
Estos consisten en:
- Extraer al ADN. Se rompen las células microbianas para separar y obtener únicamente ADN
- Se obtienen múltiples copias del gen ADNr 16S mediante la técnica “reacción en cadena de la polimerasa (o PCR por sus siglas en inglés Polimerase Chain Reaction)”
- Luego, se realiza la secuenciación. Aquí, las moléculas que componen al ADNr 16S son “leídas” por un equipo que determina el orden exacto de los nucleótidos. El resultado es una secuencia (o el código de barras) de las moléculas que componen los fragmentos del gen
- El paso final es la asignación taxonómica de las secuencias de ADN. Se emplean computadoras y modelos computacionales (o softwares) para limpiar y filtrar las secuencias, dejando solo aquellas de alta calidad. Las secuencias del gen ADNr 16S de los microbios contenidos en el pan de abeja (cultivables y no cultivables) se contrastan con bases de datos especializadas para identificar a qué microorganismos pertenecen. Los resultados son altamente precisos y revelan la diversidad y la abundancia de los grupos de bacterias del pan de abeja no observados mediante los métodos de cultivo (Figura 7).

Figura 7. Ejemplo de los resultados de secuenciación del ADN obtenido de muestras de pan de abeja, que exhiben la diversidad y abundancia de los microorganismos cultivables y no cultivables. Crédito: A. Pereira-Santana.
Aunque las técnicas modernas de secuenciación conducen a un conocimiento profundo, las técnicas tradicionales nos permiten obtener microorganismos que pueden ser cultivados en el laboratorio y posteriormente aplicados en diferentes procesos. El estudio de los microbios presentes en el “pan de abeja” puede llevar al descubrimiento de bacterias con aplicaciones biotecnológicas. Por ejemplo, ciertas bacterias acido-lácticas (BAL) reportadas en este alimento, como Fructobacillus y Lactobacillus, exhiben propiedades probióticas de gran interés para la salud humana. La producción de moléculas antimicrobianas (compuestos bioactivos de origen natural), es una de las propiedades de interés en estos microorganismos y tiene un gran potencial para su aplicación en la industria de la bio-preservación de alimentos.
El pan de abeja es esencial en la alimentación de las abejas. Entender el complejo proceso de su transformación requiere un estudio profundo de los microorganismos que contiene. La combinación de las técnicas tradicionales de cultivo de microorganismos y los métodos modernos de secuenciación masiva de ADN nos permite a los científicos descubrir la gran diversidad de microbios presentes en el pan de abeja, entender su contribución a la nutrición de estos insectos y nos permite explorar su posible aplicación para el beneficio tanto de las abejas como de los humanos.
Referencias
- Araneda, X., Velásquez, C., Morales, D., Martínez, I. (2014). Producción de pan de abejas (Apis mellifera L.) bajo condiciones de laboratorio. Idesia, 32:4, 63-69. Disponible en: https://www.scielo.cl/scielo.php?script=sci_arttext&pid=S0718-34292014000400008
- Caycedo, L., Corrales Ramírez, L.C., Trujillo Suárez, D.M. (2021). Las bacterias, su nutrición y crecimiento: una mirada desde la química. Nova, 19:36, 49-94. Disponible en: https://hemeroteca.unad.edu.co/index.php/nova/article/view/5293
- Rubio, S., Pacheco-Orozco, R.A., Gómez, A.M., Perdomo, S., García-Robles, R. (2020). Secuenciación de nueva generación (NGS) de ADN: presente y futuro en la práctica clínica. Universitas Medica, 61:2, 1-15. Disponible en: https://revistas.javeriana.edu.co/index.php/vnimedica/article/view/27461
- Vásquez, A., Olofsson, T.C. (2009). The lactic acid bacteria involved in the production of bee pollen and bee bread. Journal of Apicultural Research, 48:3, 189-195. Disponible en: https://www.tandfonline.com/doi/abs/10.3896/IBRA.1.48.3.07
Comparte este artículo en redes sociales
Acerca de los autores
El Dr. César Canché Collí egresó del Posgrado en Ciencias en el CICY; actualmente realiza una Estancia Posdoctoral en el Centro de Investigación y Asistencia y Diseño del Estado de Jalisco (CIATEJ) sede sureste, en donde investiga la microbiota de abejas sin aguijón en el sureste de México. El M. en C. Jorge Ramírez Pech tiene una Maestría en Apicultura en la Universidad Autónoma de Yucatán. Fue técnico investigador en el Departamento de Apicultura (UADY) y en las Universidades de Dusseldorf y Bochum, Alemania. Tiene 16 años de experiencia en apicultura y 14 en meliponicultura. El Dr. Alejandro Pereira Santana es Investigador por México comisionado al CIATEJ sede sureste. Posee una amplia experiencia en el estudio evolutivo de genes y genomas en múltiples organismos, manejo de datos ómicos de diversas plataformas.
Contacto: cesarcancolli@gmail.com, apereira@ciatej.mx